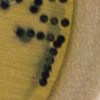

3 razones para preferir comer pescados pequeños, según estudio de Harvard
Una de las razones para comer pescados pequeños, es que además de ser ricos en vitaminas y minerales, tiene menos cantidad de mercurio en comparación con los peces de mayor tamaño
Un estudio de Harvard ofrece tres razones para comer pescados pequeños. Crédito: Shutterstock
Hay una creciente tendencia en cambios de los hábitos alimentarios de muchas personas que están comiendo más aves, pescados y productos del mar, en sustitución de las hamburguesas y embutidos. Un estudio de la Universidad de Harvard explica tres razones por las cuales mejor comer pescados pequeños que grandes.
Los expertos de Harvard señalas que estas fuentes de proteínas son mejores que la carne de res, por varias razones, como que representan una menor incidencia de riesgo de enfermedades cardíacas, diabetes y cáncer.
Además, que son mejores para el medio ambiente, ya que su producción utiliza menos tierra y otros recursos y genera menos emisiones de gases de efecto invernadero.
La recomendación de los estudiosos es preferir productos del mar que se encuentran en un eslabón inferior de la cadena alimentaria, en otras palabras peces pequeños como: el arenque, las sardinas y bivalvos como las almejas y las ostras.
Christopher Golden, profesor asistente de nutrición y salud planetaria en la Escuela de Salud Pública TH Chan de Harvard, indica que “es mucho mejor para la salud y el medio ambiente, reemplazar las fuentes de alimentos terrestres, especialmente la carne roja, con fuentes de alimentos acuáticos”.
3 razones para comer peces pequeños
Fuentes de proteínas: los peces pequeños como las anchoas, el arenque, la caballa y las sardinas son excelentes fuentes de proteínas, micronutrientes como hierro, zinc y vitamina B 12 y ácidos grasos omega-3 saludables para el corazón.
Por ser fuente de estos nutrientes, su consumo se relaciona con el alivio de la inflamación en el cuerpo y promover un mejor equilibrio de lípidos sanguíneos. También fuente de calcio y vitamina D, sobre todo cuando se come el pescado entero, incluidas las espinas diminutas.
Golden advierte que la caballa es una excepción, ya que sus huesos son demasiado afilados o duros para comer, aunque estén cocidos.
Menos carga de mercurio: Según los estudios citados por el especialista, es menos probable que “los peces pequeños contengan contaminantes como mercurio y bifenilos policlorados (PCB) en comparación con especies grandes como el atún y el pez espada”.
Explica que los peces grandes se alimentan de peces más pequeños, lo que concentra las toxinas.
Son mejores para el medio ambiente: el consumo de peces pequeños se considera más respetuosos para el medio ambiente, que emplearlos para fabricar harinas y alimentar a otros animales como el salmón, el cerdo y las aves de piscifactoría.

Golden señala que para alimentar el ganado y otros animales terrestres de consumo se utilizan cereales, que a su vez implica una inversión de recursos como tierra, agua, pesticidas y energía para producirlos.
También indicó que cada vez menos se usa la harina de pescado para las crías de salmones, y algunas empresas han creado alimentos altamente nutritivos que no requieren harina de pescado en absoluto.
Sigue leyendo:
¿Qué tan saludables son las sardinas enlatadas?
Aprende a seleccionar el mejor pescado: consejos para evitar los que no están frescos